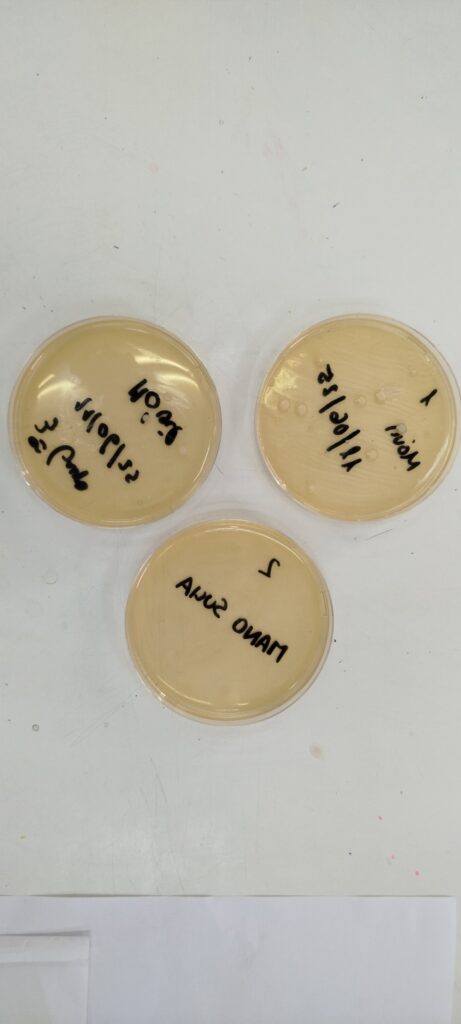

Nuestros alumnos de bachillerato concluyen sus prácticas de Biología y Física y Química del curso. En nuestro taller-laboratorio han podido realizar tanto la práctica de cultivo de microorganismo como de las de análisis de disoluciones y experimentos ácido-base.